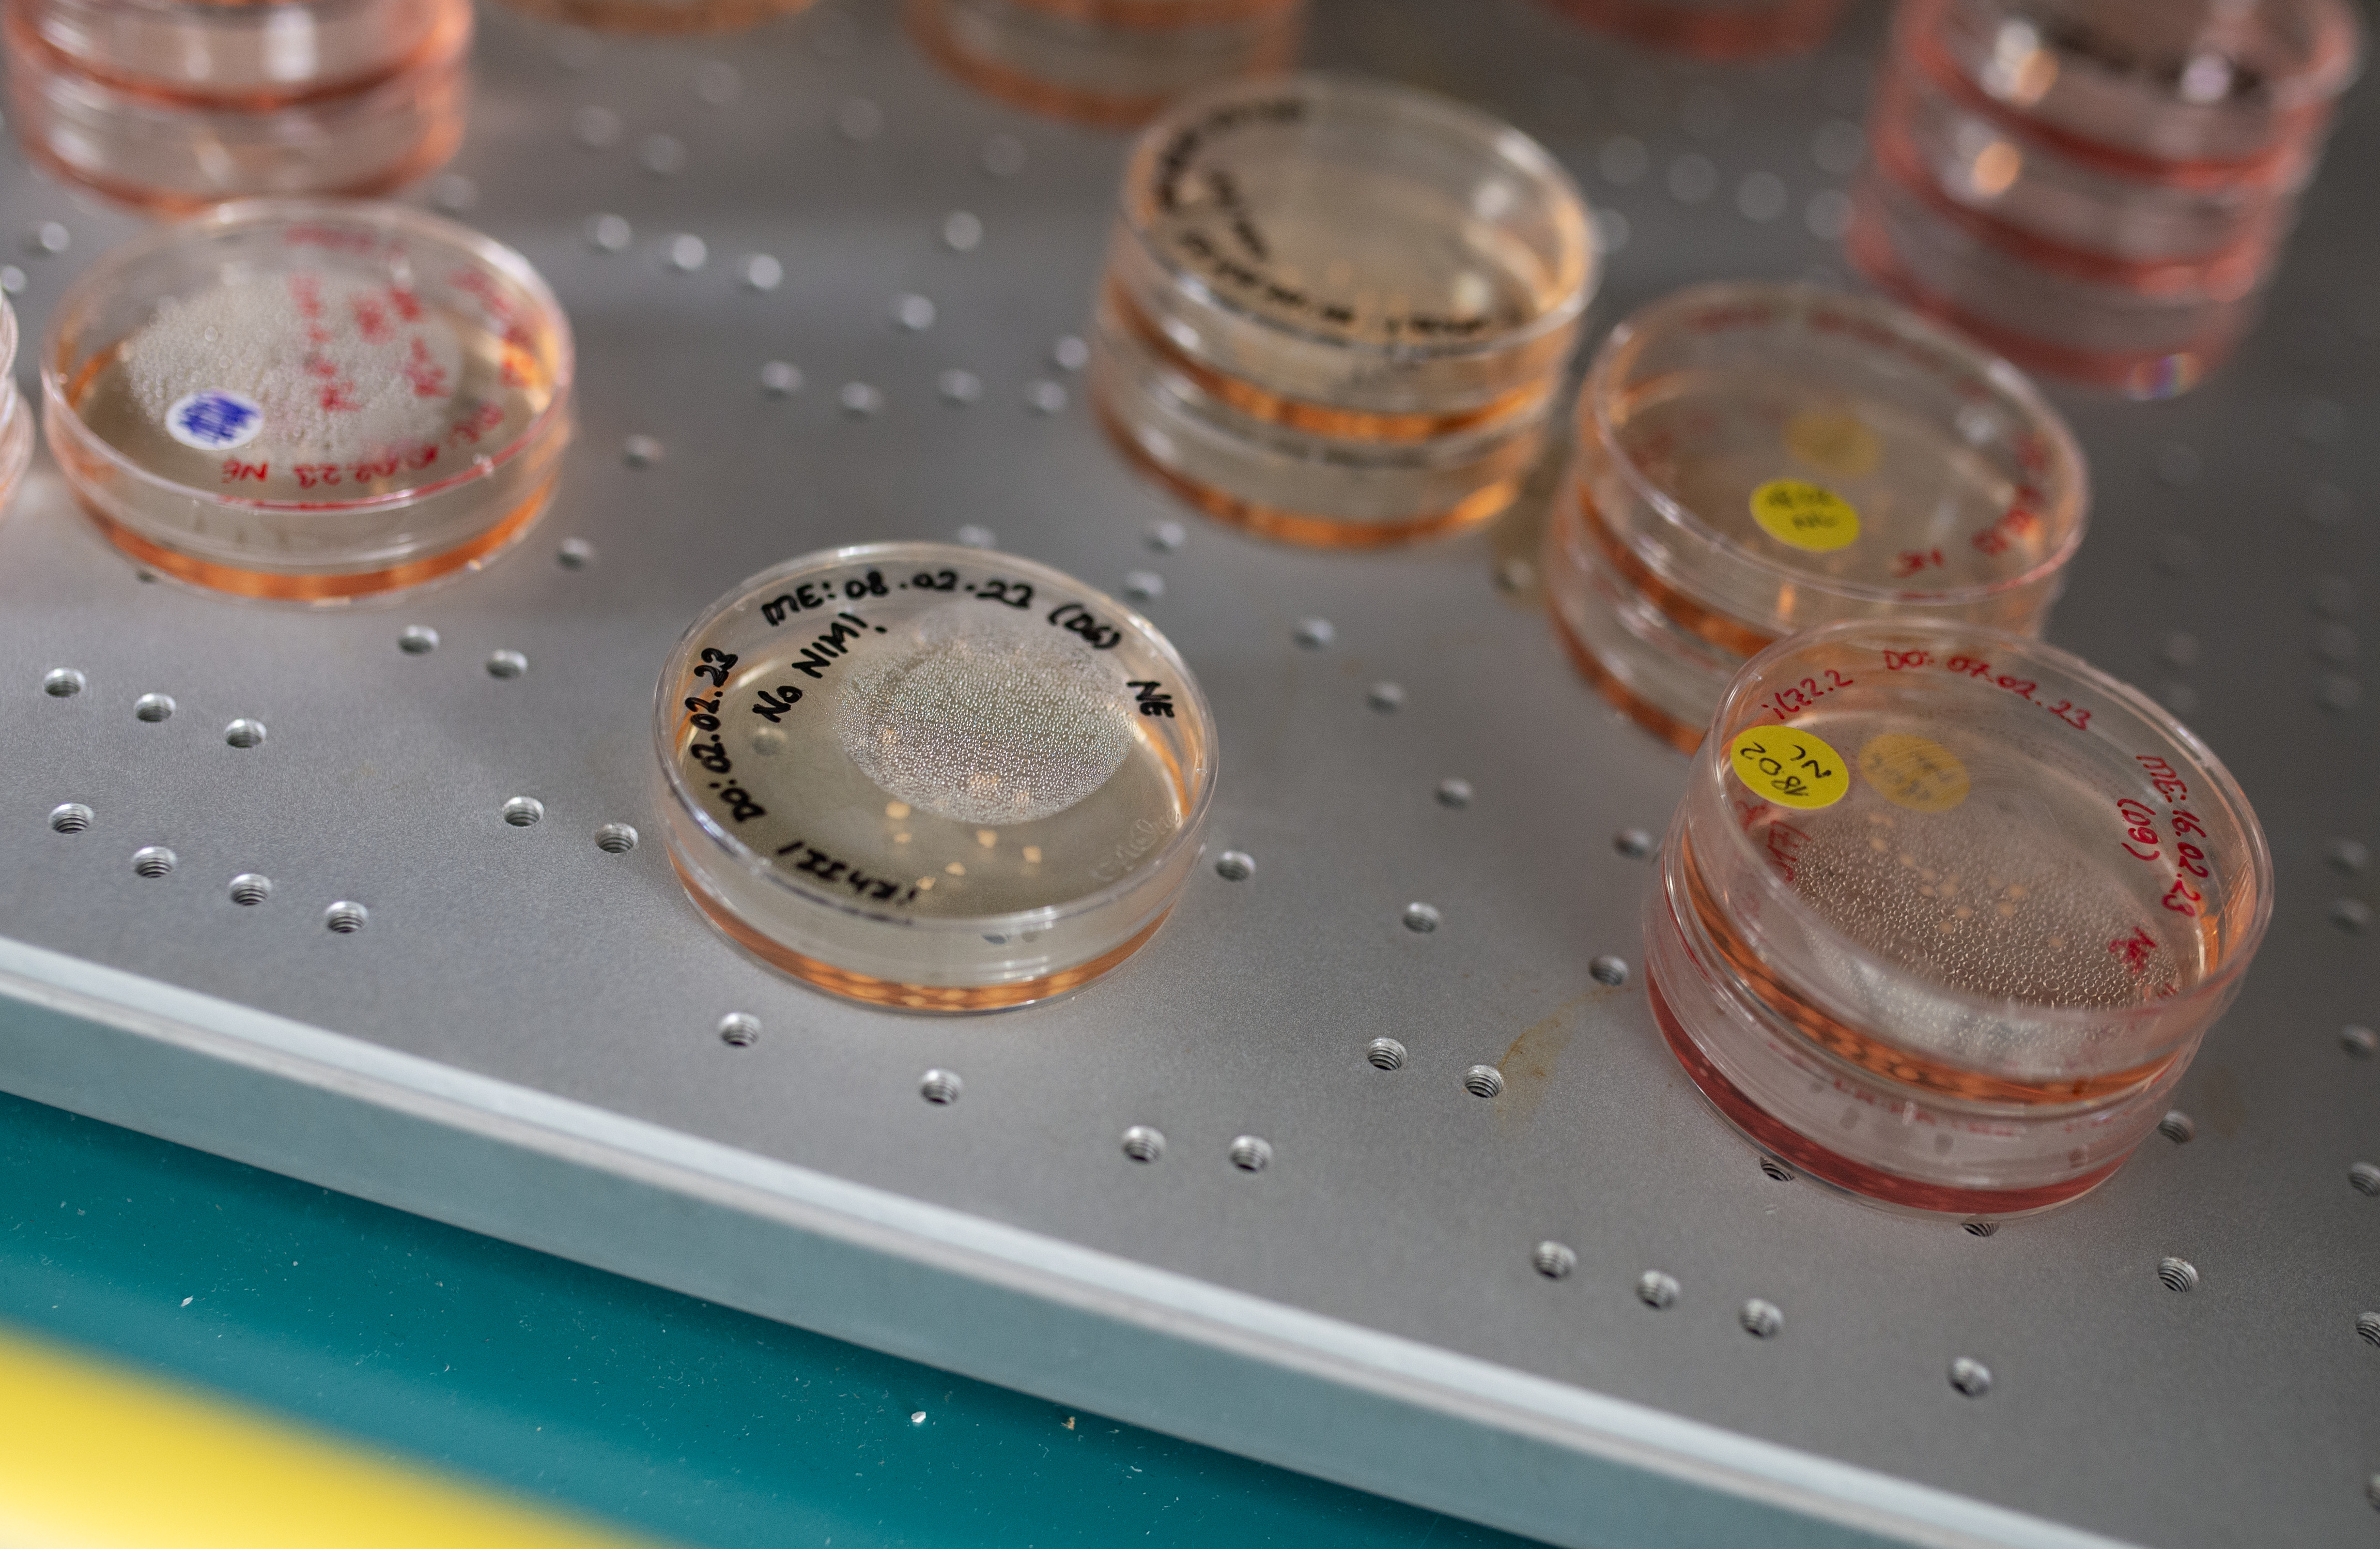

MHH-Forscherin hat mit einem internationalen Forschungsteam eine seltene Entwicklungsstörung mit menschlichen Hirn-Organoiden modelliert.
Hirnorganoide verschiedener Entwicklungsstadien im Kulturmedium in einem Brutschrank. Copyright: Karin Tilch

Eine sich teilende Zelle eines menschlichen Hirnorganoid. Copyright: Indra Niehaus/MHH
Warum entwickeln einige Kinder ein zu kleines Gehirn (Mikrozephalie)? Ein internationales Forschungsteam unter Beteiligung des Deutschen Primatenzentrums – Leibniz-Institut für Primatenforschung (DPZ), der Medizinischen Hochschule Hannover (MHH) und des Max-Planck-Instituts für molekulare Zellbiologie und Genetik hat mithilfe menschlicher Hirn-Organoide untersucht, wie Veränderungen in wichtigen Strukturproteinen der Zelle zu dieser schweren Entwicklungsstörung führen (EMBO Reports).
Mutationen in Aktin-Genen verändern die Art und Weise, wie sich frühe Vorläuferzellen im Gehirn teilen. Dadurch sinkt die Zahl dieser Zellen, was dazu führt, dass das Gehirn weniger wächst und kleiner bleibt. „Unsere Erkenntnisse liefern erstmals eine zelluläre Erklärung für die Mikrozephalie bei Menschen mit dem seltenen Baraitser-Winter-Syndrom“, sagt Indra Niehaus, Erstautorin der Studie und wissenschaftliche Mitarbeiterin an der Medizinischen Hochschule Hannover.
Eine Störung im „inneren Zellgerüst“ verändert die Gehirnentwicklung
Aktin ist ein Grundbaustein des Zellskeletts, also der inneren Stütz- und Transportstruktur jeder Zelle. Menschen mit Baraitser-Winter-Syndrom tragen eine einzelne Genveränderung in einem von zwei zentralen Aktin-Genen. Um die Wirkung dieser Mutationen zu untersuchen, erzeugten die Forschenden aus Hautzellen von Baraitser-Winter-Syndrom Patient*innen induzierte pluripotente Stammzellen. Daraus bildeten sie dreidimensionale Hirn-Organoide, die wichtige Schritte der frühen menschlichen Gehirnentwicklung nachstellen.
Die Ergebnisse waren deutlich: Nach dreißig Tagen Wachstumszeit waren die Patient*innen- Organoide rund ein Viertel kleiner als die Kontroll-Organoide von gesunden Spender*innen. Auch die inneren Ventrikel-ähnlichen Strukturen, in denen sich die Vorläuferzellen befinden und frühe Nervenzellen bilden – waren deutlich kleiner.
Weniger Stammzellen im frühen Gehirn
Ein genauer Blick auf die Zelltypen in den Organoiden zeigte eine Verschiebung: Der Anteil der apikalen Vorläuferzellen, also der zentralen Vorläuferzellpopulation der Großhirnrinde, war deutlich verringert. Gleichzeitig bildeten sich vermehrt basale Vorläuferzellen, eine Tochterzellart, die normalerweise erst später in der Entwicklung vermehrt auftritt.
Zellteilungen kippen in die falsche Richtung
Mit hochauflösender Mikroskopie analysierte das Team die Teilung der apikalen Vorläuferzellen. Normalerweise teilen sich diese Zellen überwiegend senkrecht zur Oberfläche der Ventrikelzone. Nur so werden die Zellbestandteile gleichmäßig verteilt, und zwei neue apikale Vorläuferzellen entstehen. In den Patient*innen-Organoiden war genau dieser Prozess gestört: Der Anteil der senkrechten Teilungen war massiv verringert. Stattdessen teilten sich die Mehrheit der Zellen waagerecht oder in schrägen Winkeln. Diese veränderte Orientierung führte dazu, dass sich die apikalen Vorläuferzellen seltener selbst erneuerten, häufiger aus der Ventrikelzone herauslösten und sich in basale Vorläuferzellen umwandelten.
„Unsere Analysen zeigen sehr klar, dass eine veränderte Teilungsausrichtung der Vorläuferzellen der entscheidende Auslöser für die verringerte Gehirngröße ist“, sagt Michael Heide, Gruppenleiter am Deutschen Primatenzentrum und Letztautor der
Studie. „Eine einzelne Veränderung im Zellskelett reicht aus, um den Ablauf der frühen Gehirnentwicklung entscheidend zu verändern.“
Feinste strukturelle Abweichungen mit großen Folgen
Elektronenmikroskopische Aufnahmen zeigten weitere Auffälligkeiten: Die Zellformen im Bereich der Ventrikelzone waren unregelmäßig. Es fanden sich mehr Ausstülpungen zwischen benachbarten Zellen. Zudem lag an den Zellverbindungen ungewöhnlich viel Tubulin vor, ein anderer Baustein des Zellskeletts, der eine wichtige Rolle bei der Zellteilung spielt. Obwohl die grundlegende Zellarchitektur noch erkennbar war, könnten diese Veränderungen ausreichen, um die Teilungsausrichtung dauerhaft zu stören.
Genetischer Beweis: Eine einzelne Mutation genügt
Um auszuschließen, dass Unterschiede zwischen Patient*innen- und Kontroll-Organoiden auf andere genetische Faktoren zurückzuführen sind, führte das Team ein Kontrollexperiment durch: Die gesunde Stammzelllinie wurde mit CRISPR/Cas9 so verändert, dass sie exakt dieselbe Mutation trug wie eine der Baraitser-Winter-Syndrom Patient*innen. Das Ergebnis: Die so erzeugten Hirn-Organoide zeigten die gleichen Fehlentwicklungen wie die patientenabgeleiteten Organoide – ein Beleg, dass die Mutation selbst die Ursache ist.
Was bedeutet das für Medizin und Forschung?
„Unsere Ergebnisse helfen zu verstehen, wie seltene genetische Erkrankungen komplexe Hirnfehlbildungen hervorrufen können und sie zeigen, welches Potenzial Hirn-Organoide für die biomedizinische Forschung haben“, sagt Michael Heide. „Das therapeutische Potential dieser Studie liegt einmal in der Diagnostik, da unsere Daten helfen, genetische Befunde bei Patient*innen besser einzuordnen. Da bei der Erkrankung frühe fötale Entwicklungsprozesse betroffen sind, wären Eingriffe beim Menschen komplex. Neue Medikamente, die das Zusammenspiel von Aktin und Mikrotubuli beeinflussen,
könnten jedoch langfristig neue Ansätze eröffnen“, so Nataliya Di Donato, Direktorin des Instituts für Humangenetik an der Medizinischen Hochschule Hannover.
Text: DPZ/MHH